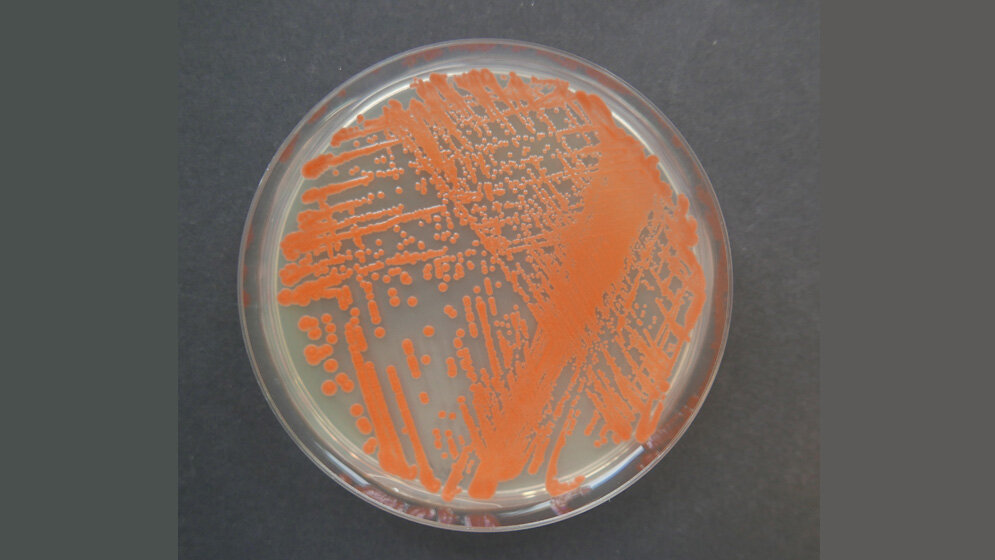
Reinkultur der Roten Hefe Rhodotorula mucilaginosa

Für die Wissenschaftler der Arbeitsgruppe Botanische Genetik und Molekularbiologie an der Universität Kiel unter der Leitung von Professor Frank Kempken bot sich eine einmalige Gelegenheit. Über das Institut für Geowissenschaften der CAU erlangte die Gruppe Zugang zu Tiefsee-Sedimentproben des Mittelatlantischen Rückens aus 1.600 m bis 4.000 m Tiefe, die während einer Forschungsfahrt mit dem deutschen Forschungsschiff MARIA S. MERIAN gewonnen wurden. Die Forscher um Prof. Kempken konnten aus einem dieser Sedimentkerne aus 3.600 m Tiefe erfolgreich lebende Pilzkulturen der Gattung Rhodotorula mucilaginosa isolieren und anzüchten. Die langsam wachsende Pilzart gehört zu den sogenannten Basidiomyceten und ist nicht mit der bekannteren Bäckerhefe zu verwechseln. Diese spezielle Art wächst normalerweise in großer Meerestiefe und ist an den dort herrschenden hohen hydrostatischen Druck und sehr niedrige Temperaturen angepasst.
Wachstum auch bei Raumtemperatur und unter Atmosphärendruck
„Mit der angewandten Methodik ist es uns gelungen, Hefekulturen zu kultivieren, die auch bei Raumtemperatur und unter Atmosphärendruck wachsen können“, sagt Professor Kempken. „Die Experimente haben auch gezeigt, dass besondere ökologische Nischen Mikroorganismen mit besonderen Eigenschaften hervorbringen. Unsere Vermutung über die hohe Anpassungsfähigkeit der Roten Hefe hat uns zudem ermutigt, diese Art weiter zu analysieren“, erklärt Professor Kempken, dessen Forschungsgruppe sich bereits seit mehr als zehn Jahren mit der genetischen Analyse mariner Pilze beschäftigt. So konnte Postdoktorand Dr. Abhishek Kumar (CAU), der gemeinsam mit Dr. Larissa Büdenbender vom GEOMAR Erstautor der Studie ist, durch Kombination von Millionen sequenzierter DNA-Fragmente das Genom des Rhodotorula mucilaginosa-Isolates zusammensetzen. Außerdem konnten Gene für wichtige Komponenten des Biosynthesewegs von Glykolipiden identifiziert werden. Dieser ist besonders wichtig im Hinblick auf die Entwicklung von Naturstoffen zur Anwendung in Medizin und Biotechnologie sowie der Chemie, Lebensmittel-Industrie oder Landwirtschaft.
Untersuchung bei verschiedenen Wachstumsbedingungen
Die Analyse des gesamten Wirkstoff-Potenzials eines Pilzes ist schwierig, da viele Naturstoffe auch in ihrer natürlichen Umgebung nur unter ganz bestimmten Voraussetzungen produziert werden. Es ist schlicht unmöglich, die natürlichen Gegebenheiten der Tiefsee im Labor nachzustellen. Daher entschieden die Leiterin der Forschungseinheit Marine Naturstoffchemie am GEMOAR und des GEOMAR-Biotech, Professor Deniz Tasdemir, und Dr. Büdenbender, die Metabolitproduktion und die Bioaktivität der roten Hefepilze unter unterschiedlichen Wachstumsbedingungen zu untersuchen. Professor Tasdemir erklärt: „Wir konnten medium-abhängig unterschiedliche, entweder krebshemmende oder antimikrobielle Bioaktivität beobachten.“
Metabolom der Hefe-Extrakte untersucht
Als Nächstes untersuchten die Forscher die chemische Zusammensetzung, das sogenannte Metabolom der Hefe-Extrakte. Dazu nutzten sie Algorithmus-basierte automatisierte Methoden der Metabolomik. Es zeigte sich, dass die rote Hefe ganz besonders reich an so genannten Fettsäure-Polyol-Estern (PEFAs) ist. Diese Glykolipide sind phosphorfreie Strukturbestandteile der Zellmembranen und schützen die Hefe möglicherweise vor dem hydrostatischen Druck im Lebensraum Tiefsee. „Im ersten Schritt unserer Untersuchungen fanden wir Dutzende solcher Verbindungen in der Roten Hefe und konnten so die Erforschung des Genoms unserer Kollegen an der Universität Kiel unterstützen“, so Professor Tasdemir. Dr. Büdenbender verfolgte einen gezielten Ansatz zur Aufreinigung dieser aufgrund ihrer hohen strukturellen Ähnlichkeit zueinander schwer zu isolierenden Moleküle. Professor Tasdemir weiter: „Mehrere der isolierten PEFAs waren vorher nicht beschrieben und wir konnten erstmals ihre sehr komplexe chemische Struktur aufklären. Es sieht so aus, dass diese Verbindungen bei gemeinsamem Vorliegen eine stärkere Wirkung gegen Krebs haben. Wir erforschen nun die Gründe für diese Synergieeffekte.“
Entwicklung neuer Medikamente?
Durch die erfolgreiche Zusammenarbeit der beiden Arbeitsgruppen am GEOMAR und der Universität Kiel unter Anwendung verschiedener „omics“- Methodiken konnten Erkenntnisse zur Biosynthese neuartiger Naturstoffe eines Tiefsee-Pilzes sowohl auf DNA- als auch auf chemischer Ebene gewonnen werden. Die Ergebnisse aus der Untersuchung dieser ölhaltigen roten Hefe könnten einen wertvollen Beitrag für die Entwicklung neuer Medikamente leisten. Sie könnten zukünftig aber zudem auch für andere biotechnologische Anwendungen in der Lebensmittel- oder der chemischen Industrie, der Landwirtschaft oder bei Biokraftstoffen von Bedeutung sein.
Buedenbender L, Kumar A, Blümel M, Kempken F, Tasdemir D (2021): Genomics- and metabolomics-based investigation of the deep-sea sediment-derived yeast, Rhodotorula mucilaginosa 50-3-19/20B. Marine Drugs, 19, 14, DOI: 10.3390/md19010014.
Quelle: idw/GEOMAR
Artikel teilen